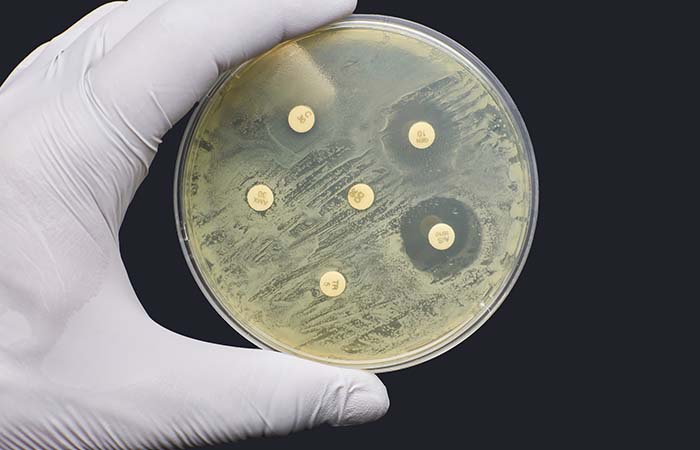

No rise in nitrofurantoin resistance since Pharmacy First UTI launch
In Health & NHS news
Follow this topic
Bookmark
Record learning outcomes
Improved access to treatment for uncomplicated UTI infections through Pharmacy First has not led to increased resistance to the antibiotic nitrofurantoin, the UK Health Security Agency has said.
Publishing data for 2024 and 2025 from its antimicrobial surveillance programme, the UKHSA said “no change” in nitrofurantoin resistance in lower UTI patients was observed between 2023 and the introduction of the Pharmacy First clinical pathways in February 2024, the analysis found. The resistance rate for nitrofurantoin to treat lower UTIs was 2.2 per cent in 2024.
This was despite the fact that supplying an antimicrobial was by far the most common intervention following a UTI pathway consultation, with this taking place in 85 per cent of cases.
For the acute sore throat pathway, the most commonly used with 806,491 consultations between April 2024 and March 2025, the rate of antibiotic supply was 65 per cent.
The UKHSA analysis found that although total antibiotic consumption in 2024 was two per cent lower than in 2019 and prescribing rates “slightly lower… across most settings,” the ‘Other community’ setting in which Pharmacy First is placed has seen a 43.8 per cent increase (from 0.74 to 1.06 per 1,000 inhabitants per day).
“The rise in ‘Other community’ consumption is largely attributed to the introduction of the Pharmacy First service in 2024 and now represents 34.5 per cent of antibiotic use within the ‘Other community’ setting,” said the report authors.
The UKHSA said there has been a “notable” increase in antibiotic supply through Pharmacy First but added that this should be “interpreted with caution,” commenting: “The service follows established clinical protocols based on guidance from the NICE and diagnostic pathways developed by the UKHSA, supporting appropriate prescribing.
“The observed increase may reflect a shift in patient pathways from other settings — including independent sector medical services, emergency departments, and some walk-in or urgent treatment centres – rather than a simple increase in antibiotic demand.”
Almost 400 resistant infections every week
The UKHSA analysis revealed there almost 400 antibiotic-resistant infections each week in 2024.
UKHSA chief executive Susan Hopkins said: “More people than ever are acquiring infections that cannot be effectively treated by antibiotics. This puts them at greater risk of serious illness and even death, with our poorest communities hit the hardest.